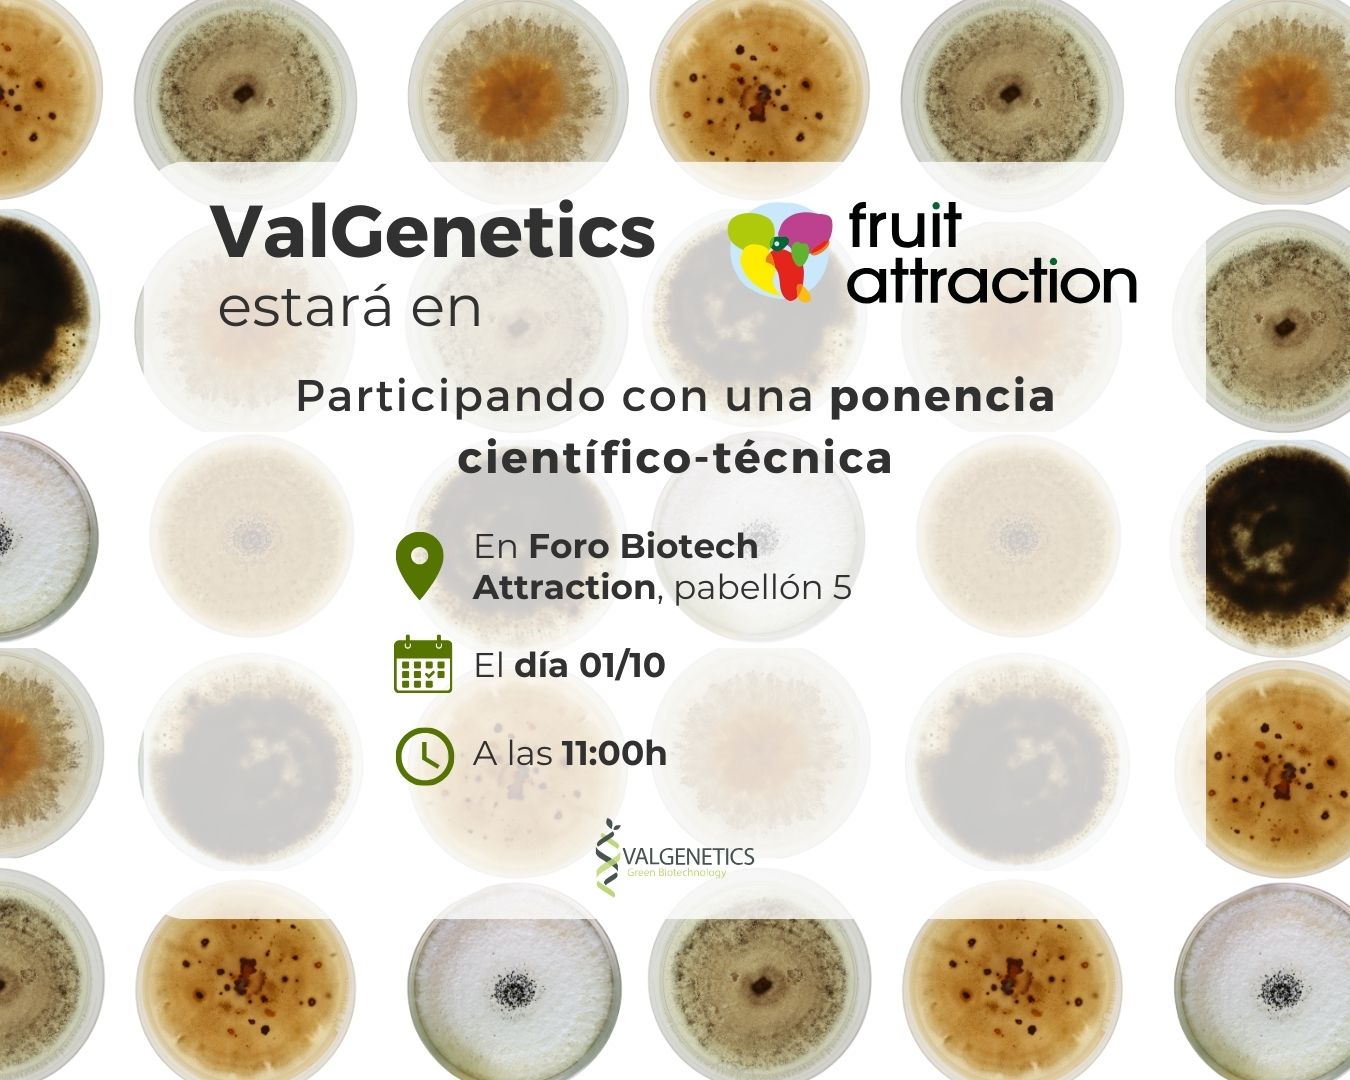

Presentamos la plataforma Ecoefficacy en Fruit Attraction
Participamos como expositores en la próxima edición de Fruit Attraction, donde además la doctora Ana Crespo Sempere, directora del departamento de Fitopatología y Microbiología Vegetal ofrecerá una charla científico-técnica para dar a conocer los avances de la nueva plataforma Ecoefficacy.
Ecoefficacy es una herramienta pionera que integra resultados de análisis bioquímicos, biológicos, microbiológicos y moleculares, permitiendo comparar productos, visualizar su viabilidad y modo de acción, y seleccionar las soluciones más adecuadas según las condiciones ambientales.
Con esta propuesta, se refuerza el compromiso con la innovación y el apoyo a los profesionales del sector hortofrutícola en la toma de decisiones basadas en datos científicos.
